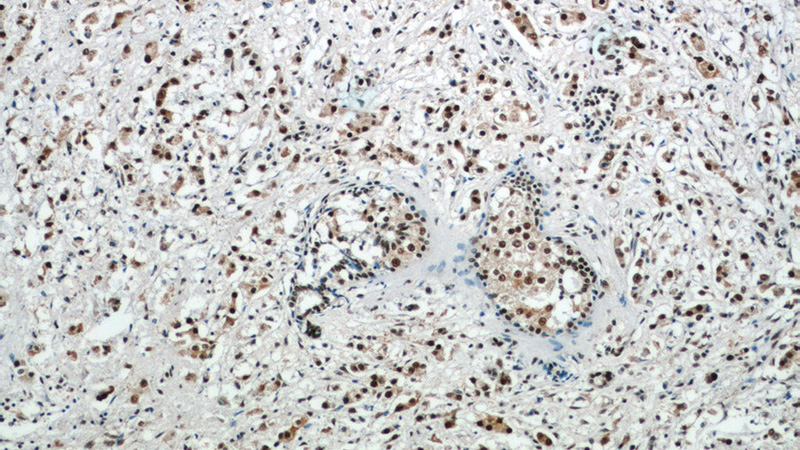
Immunohistochemistry of paraffin-embedded human breast cancer tissue slide using Catalog No:111828(IRAK1 Antibody) at dilution of 1:50 (under 10x lens)

-
Product Name
IRAK1 antibody
- Documents
-
Description
IRAK1 Rabbit Polyclonal antibody. Positive IHC detected in human breast cancer tissue, human lung cancer tissue. Positive IF detected in A549 cells. Positive FC detected in HeLa cells. Positive WB detected in A549 cells, HeLa cells, PC-13 cells. Positive IP detected in HeLa cells. Observed molecular weight by Western-blot: 68-80 kDa
-
Tested applications
ELISA, WB, IP, IHC, IF, FC
-
Species reactivity
Human,Mouse,Rat; other species not tested.
-
Alternative names
IRAK antibody; IRAK 1 antibody; IRAK1 antibody; pelle antibody
-
Isotype
Rabbit IgG
-
Preparation
This antibody was obtained by immunization of IRAK1 recombinant protein (Accession Number: NM_001025243). Purification method: Antigen affinity purified.
-
Clonality
Polyclonal
-
Formulation
PBS with 0.1% sodium azide and 50% glycerol pH 7.3.
-
Storage instructions
Store at -20℃. DO NOT ALIQUOT
-
Applications
Recommended Dilution:
WB: 1:200-1:2000
IP: 1:200-1:2000
IHC: 1:50-1:500
IF: 1:50-1:500
-
Validations

A549 cells were subjected to SDS PAGE followed by western blot with Catalog No:111828(IRAK1 Antibody) at dilution of 1:600
Immunohistochemistry of paraffin-embedded human breast cancer tissue slide using Catalog No:111828(IRAK1 Antibody) at dilution of 1:50 (under 10x lens)

Immunohistochemistry of paraffin-embedded human breast cancer tissue slide using Catalog No:111828(IRAK1 Antibody) at dilution of 1:50 (under 40x lens)

Immunofluorescent analysis of (10% Formaldehyde) fixed A549 cells using Catalog No:111828(IRAK1 Antibody) at dilution of 1:50 and Alexa Fluor 488-congugated AffiniPure Goat Anti-Rabbit IgG(H+L)

1X10^6 HeLa cells were stained with .2ug IRAK1 antibody (Catalog No:111828, red) and control antibody (blue). Fixed with 4% PFA blocked with 3% BSA (30 min). Alexa Fluor 488-congugated AffiniPure Goat Anti-Rabbit IgG(H+L) with dilution 1:1500.
-
Background
Interleukin-1 receptor-associated kinases (IRAKs) are a unique family of death domain containing protein kinases that play a key role in initiating innate immune response against foreign pathogens. They are involved in Toll-like receptor (TLR) and interleukin-1 receptor (IL-1R) signaling pathways. IRAK1 is the first member of this kinase family. Upon ligand binding to TLR/IL-1R, IRAK1 is recruited by MYD88 to the receptor-signaling complex, the association leads to IRAK1 phosphorylation by IRAK4 and subsequent autophosphorylation and kinase activation. Hyper-phosphorylated IRAK1 then disengages from the receptor complex, and forms a cytosolic IRAK1-TRAF6 complex. TRAF6 then interacts with TAK and TAB, resulting in eventual activation of the NF-κB and MAPK pathways. Phosphorylated IRAK1 also undergoes ubiquitin-mediated degradation or sumoylation, which results in nuclear translocation and transcriptional activation of inflammatory target genes. (PMID: 17890055; 12620219)
-
References
- Jiang M, Xiang Y, Wang D. Dysregulated expression of miR-146a contributes to age-related dysfunction of macrophages. Aging cell. 11(1):29-40. 2012.
- Sun Y, Varambally S, Maher CA. Targeting of microRNA-142-3p in dendritic cells regulates endotoxin-induced mortality. Blood. 117(23):6172-83. 2011.
Related Products / Services
Please note: All products are "FOR RESEARCH USE ONLY AND ARE NOT INTENDED FOR DIAGNOSTIC OR THERAPEUTIC USE"
